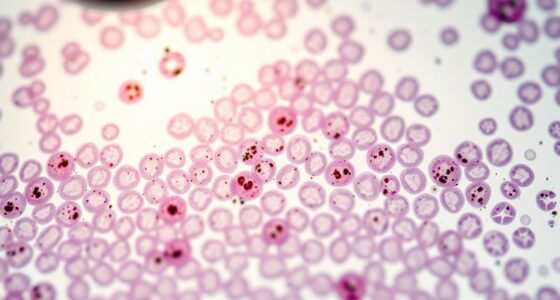
Tumorgrad und Ki-67

Präkanzeröse Veränderungen wie DCIS und LCIS weisen auf unterschiedliche Risikostufen für die Entwicklung von Brustkrebs hin. DCIS ist auf die Milchgänge beschränkt, kann aber ohne Behandlung zu invasivem Krebs fortschreiten, während LCIS in den Drüsenläppchen auftritt und hauptsächlich auf ein erhöhtes Risiko hinweist, anstatt direkt fortzuschreiten. Das Verständnis dieser Zustände hilft dabei, ihre Bedeutung für Früherkennung und Behandlung zu erfassen. Wenn Sie wissen möchten, wie diese Anzeichen die Diagnose und Behandlungsmöglichkeiten beeinflussen, gibt es weiter unten mehr dazu zu entdecken.
Wichtige Erkenntnisse
- DCIS ist eine nicht-invasive Läsion, die innerhalb der Milchgänge begrenzt ist und ein erhebliches Potenzial zur Progression zu invasivem Brustkrebs aufweist, wenn sie unbehandelt bleibt.
- LCIS zeigt ein erhöhtes zukünftiges Risiko für bilateralen invasiven Brustkrebs, gilt jedoch nicht als direkter Vorläufer der invasiven Erkrankung.
- Fortschritte in der Screening-Technologie haben die Erkennung präkanzeröser Brustläsionen erhöht, was die Behandlungsstrategien und Ergebnisse beeinflusst.
- Molekulare Profilierung und personalisierte Risikoabschätzung verbessern die Unterscheidung zwischen Läsionen, die eine Intervention erfordern, und solchen, die für eine Überwachung geeignet sind.
- Früherkennung und angemessene Behandlung von DCIS und LCIS sind entscheidend, um das Progressionsrisiko zu verringern und langfristige Brustkrebs-Ergebnisse zu optimieren.
Mammographie Brustkrebs Früherkennung
As an affiliate, we earn on qualifying purchases.
As an affiliate, we earn on qualifying purchases.
Verstehen von DCIS und LCIS: Definitionen und Unterschiede

Um die Unterschiede zwischen DCIS und LCIS zu verstehen, ist es wichtig zu erkennen, dass sie unterschiedliche präkanzeröse Zustände sind, die verschiedene Bereiche des Brustgewebes betreffen. DCIS, oder ductales Carcinoma in situ, betrifft abnormale Zellen, die innerhalb der Milchgänge eingeschlossen sind. Es gilt als eine nicht-invasive Phase von Brustkrebs, ist oft asymptomatisch und wird typischerweise durch Mammographie entdeckt. Im Gegensatz dazu hat LCIS, oder lobuläres Carcinoma in situ, seinen Ursprung in den Milchgängen (Lobuli). Es ist kein echter Krebs, sondern weist auf ein erhöhtes Risiko hin, später in invasiven Brustkrebs überzugehen. Während DCIS ohne Behandlung in invasiven duktalen Karzinom fortschreiten kann, dient LCIS hauptsächlich als Marker für ein erhöhtes Risiko, anstatt ein direkter Vorläufer zu sein. Das Verständnis dieser Unterschiede hilft, geeignete Überwachungs- und Behandlungsstrategien zu entwickeln. Zudem verbessern Fortschritte in KI in der Bildung** die Diagnosewerkzeuge und personalisierten Behandlungspläne für Brustkrebspatienten.
Brustkrebs Screening Kit
As an affiliate, we earn on qualifying purchases.
As an affiliate, we earn on qualifying purchases.
Die zunehmende Häufigkeit von ductalem Karzinom in situ

Die Inzidenz von ductalem Carcinom in situ (DCIS) ist seit den 1980er Jahren dramatisch gestiegen, was vor allem auf Fortschritte in der Screening-Technologie zurückzuführen ist. Mit weit verbreitetem Mammographie-Screening ist es wahrscheinlicher geworden, diese frühen, nicht-invasiven Läsionen zu erkennen, bevor sie Symptome verursachen. Der Anstieg war besonders deutlich und stieg etwa um 500 % von 1983 bis 2003. Seit etwa 2010 haben sich die Erkennungsraten bei etwa 40 Fällen pro 100.000 Frauen ab 20 Jahren stabilisiert. Dieser Anstieg ist hauptsächlich darauf zurückzuführen, dass Mammographien die Identifizierung kleiner, asymptomatischer DCIS-Läsionen ermöglichen, die früher unbemerkt geblieben wären. Obwohl die Gesamterkennung zugenommen hat, spiegelt der Trend eher verbesserte Screening-Methoden wider als eine tatsächliche Zunahme der Krankheitsprävalenz. Mammographie-Screening hat eine entscheidende Rolle bei diesem Trend gespielt und unterstreicht die Bedeutung der Früherkennung. Diese Veränderungen haben bedeutende Auswirkungen auf Behandlungs- und Managementstrategien.
Brustkrebsvorsorge Test
As an affiliate, we earn on qualifying purchases.
As an affiliate, we earn on qualifying purchases.
Lobuläres Carcinoma in situ: Ein Marker für erhöhtes Risiko

Lobuläres Carcinoma in situ (LCIS) dient als bedeutender Marker für ein erhöhtes Brustkrebsrisiko, anstatt eine echte präkanzeröse Läsion zu sein. Wenn LCIS diagnostiziert wird, weist dies auf eine höhere Wahrscheinlichkeit hin, dass sich im Laufe der Zeit invasive Brustkrebserkrankungen in beiden Brüsten entwickeln, aber es wandelt sich selten direkt in invasive Erkrankung um. Sie sollten verstehen, dass LCIS in den Lobuli entsteht, nicht in den Milchkanälen, und abnormale Zellproliferation ohne Invasion widerspiegelt. Das Vorhandensein signalisiert eine breitere Feldveränderung im Brustgewebe, was auf ein erhöhtes Risiko hinweist, anstatt unmittelbare Gefahr darzustellen. Das Management umfasst typischerweise eine sorgfältige Überwachung und Risikoreduktionsstrategien anstelle einer aggressiven Behandlung. Das Erkennen von LCIS als Risikomarker hilft Ihnen und Ihrem medizinischen Team, geeignete Überwachungs- und Präventionsmaßnahmen zu planen.
Brustkrebs Risikoüberwachung Geräte
As an affiliate, we earn on qualifying purchases.
As an affiliate, we earn on qualifying purchases.
Pathologische Merkmale und Klassifikation von DCIS und LCIS

Das Verständnis der pathologischen Merkmale und der Klassifikation von DCIS und LCIS ist entscheidend für eine genaue Diagnose und Behandlung. DCIS, auf die Milchgänge beschränkt, erscheint als anormale Zellproliferation, die die Basalmembran nicht durchbricht. Es wird in Untertypen wie Komedo und Nicht-Komedo eingeteilt, die sich in Wachstumsmustern und Progressionsrisiko unterscheiden. LCIS entsteht in den Lobuli und gilt eher als Risikomarker denn als echtes Krebsleiden. Es zeigt einfache, kleine Zellen, die die Lobuli füllen, oft mit klassischen lobulären Merkmalen. Die Klassifikation basiert auf dem histologischen Erscheinungsbild, der Zellarchitektur und molekularen Markern. Das Erkennen dieser Merkmale hilft, nicht-invasiven von invasiven Läsionen zu unterscheiden und die Behandlungsentscheidungen zu lenken. Der Einsatz von molekularen Markern verbessert die Genauigkeit der Klassifikation und unterstützt personalisierte Behandlungsansätze.
Fortschrittsrisiken und langfristige Ergebnisse

Sie sollten verstehen, dass unbehandeltes DCIS eine Wahrscheinlichkeit von 25–60 % hat, im Laufe der Zeit zu Krebs im Invasivstadium fortzuschreiten. Das Risiko variiert je nach Tumorbiologie und Patientenfaktoren und beeinflusst die langfristigen Ergebnisse. Während viele Frauen mit Behandlung gut zurechtkommen, sind einige einem erhöhten Sterberisiko ausgesetzt, insbesondere jüngere oder schwarze Frauen, was die Bedeutung einer personalisierten Behandlung unterstreicht.
Risiko des invasiven Übergangs
Das Risiko eines Invasivwandels bei präkanzerösen Brustläsionen variiert erheblich in Abhängigkeit vom Läsionstyp und biologischen Faktoren. Es ist wichtig zu verstehen, dass unbehandelte DCIS eine Wahrscheinlichkeit von 25–60 % hat, im Laufe der Zeit in invasiven ductalen Karzinom umzuwandeln. Im Gegensatz dazu ist LCIS eher ein Marker für ein erhöhtes Risiko als ein direkter Vorläufer, mit einer niedrigeren, aber beständigen Wahrscheinlichkeit, in beiden Brüsten invasiven Krebs zu entwickeln. Schlüssel-Faktoren, die das Risiko des Wandels beeinflussen, umfassen Läsionstyp, molekulare Marker und Mikroumfeld-Veränderungen. Man sollte bedenken, dass einige DCIS-Läsionen indolent bleiben, was die Entscheidungsfindung in der Behandlung erschwert. Das Erkennen dieser Risiken hilft bei der Steuerung der Behandlungsstrategien und Langzeitüberwachung, um eine invasive Progression zu verhindern und gleichzeitig Überbehandlung zu vermeiden.
Zusätzlich hebt die aufkommende Forschung die Bedeutung von geprüften Screening-Methoden hervor, um die Früherkennung zu verbessern und die Interventionspläne individuell anzupassen.
Langfristige Überlebensaussichten
Langzeitüberlebensraten bei Frauen, die mit präkanzerösen Brustläsionen diagnostiziert wurden, hängen vom Risiko des Fortschreitens zu invasivem Krebs und der Wirksamkeit der aktuellen Behandlungsstrategien ab. Wenn DCIS unbehandelt bleibt, besteht eine Wahrscheinlichkeit von 25–60 %, dass es sich im Laufe der Zeit in invasiven duktalen Karzinom verwandelt. Früherkennung durch Mammographie ermöglicht eine rechtzeitige Behandlung, was die Prognose erheblich verbessert. Die meisten Frauen mit angemessen behandeltem DCIS oder LCIS weisen ausgezeichnete Langzeitüberlebensraten auf, wobei die Sterblichkeit gering bleibt. Allerdings können einige Fälle Jahre später fortschreiten, was die Bedeutung einer kontinuierlichen Überwachung unterstreicht. Jüngere Frauen und bestimmte ethnische Gruppen sind einem höheren Risiko ausgesetzt. Fortschritte in der personalisierten Behandlung und molekularen Profilierung zielen darauf ab, Überbehandlung zu reduzieren und die Langzeitresultate zu verbessern, damit Sie eine auf Sie zugeschnittene Versorgung erhalten, die die Überlebenschancen maximiert. Die Integration von natürlichen Materialien wie Holz und Leinen in Behandlungsumgebungen kann einen ganzheitlichen Ansatz für Gesundheit und Wohlbefinden unterstützen.
Faktoren, die Risiko und Erkennung beeinflussen

Mehrere Faktoren beeinflussen das Risiko, präkanzeröse Brustmaleile wie DCIS und LCIS zu entwickeln, sowie die Leichtigkeit ihrer Erkennung. Sie sollten berücksichtigen, dass Screening-Methoden, Alter und die Beschaffenheit des Brustgewebes eine bedeutende Rolle spielen. Frauen über 50 Jahre oder mit dichtem Brustgewebe werden eher durch Mammographie entdeckt. Zusätzlich erhöhen familiäre Vorbelastung mit Brustkrebs und Hormontherapien Ihr Risiko, weshalb regelmäßige Vorsorgeuntersuchungen unerlässlich sind. Rassische Unterschiede beeinflussen ebenfalls die Erkennung und Ergebnisse, wobei schwarze Frauen oft einem höheren Risiko ausgesetzt sind. Lebensstilfaktoren wie Alkoholkonsum und Fettleibigkeit beeinflussen das Risiko zusätzlich. Früherkennung hängt von hochwertiger Bildgebung und Bewusstsein ab. Ein gut organisiertes Vorsorgeprogramm und eine personalisierte Risikobewertung sind entscheidend, um Läsionen zu identifizieren, bevor sie fortschreiten.
Mehrere Faktoren, einschließlich Alter, Brustdichte, Genetik und Lebensstil, beeinflussen das Risiko und die Erkennung von Brustläsionen.
- Mammographie-Technologie und -Qualität
- Brustdichte und Gewebszusammensetzung
- Genetische Veranlagung und Familiengeschichte
- Lebensstil- und Umwelteinflüsse
Aktuelle Strategien und zukünftige Entwicklungen im Management

Fortschritte in der diagnostischen Bildgebung und molekulare Profilierung prägen die aktuellen Managementstrategien für präkanzeröse Brustläsionen wie DCIS und LCIS. Sie verfügen jetzt über präzisere Werkzeuge zur Beurteilung der Läsionsmerkmale, die Ihnen bei der Entscheidung zwischen aktiver Überwachung oder Eingreifen helfen. Personalisierte Ansätze berücksichtigen Tumorbiologie, Risikofaktoren der Patientin und Präferenzen, um Überbehandlung zu vermeiden. Bei DCIS bleibt die Lumpektomie in Kombination mit Bestrahlung Standard, aber laufende Studien untersuchen eine aktive Überwachung bei niedrig-risikoreichen Fällen. Die Behandlung von LCIS umfasst häufig Risikoreduzierende Strategien wie Lebensstiländerungen und Chemoprävention, anstatt sofortiger Operationen. Zukünftige Entwicklungen konzentrieren sich auf die Identifizierung molekularer Marker, die den Fortschritt vorhersagen, sodass individuell angepasste Therapien ermöglicht werden. Technologien wie genomische Profilierung und Flüssigbiopsien versprechen eine genauere Risikoabschätzung, was letztlich zu besseren Ergebnissen führt und unnötige Behandlungen für Sie minimiert.
Häufig gestellte Fragen
Welche genetischen Faktoren beeinflussen die Entwicklung von DCIS und LCIS?
Sie sollten wissen, dass genetische Faktoren wie BRCA1- und BRCA2-Mutationen die Entwicklung von DCIS und LCIS erheblich beeinflussen. Diese Mutationen erhöhen Ihr Risiko für Brustkrebs, einschließlich in situ Läsionen. Familiengeschichte spielt ebenfalls eine Rolle, da erbliche genetische Veranlagungen Ihre Wahrscheinlichkeit, diese Erkrankungen zu entwickeln, erhöhen können. Während die Forschung weiter voranschreitet, hilft das Verständnis Ihrer genetischen Vorgeschichte dabei, Ihr Risiko einzuschätzen und personalisierte Screening- und Präventionsstrategien zu entwickeln.
Wie beeinflussen Lebensstilentscheidungen das Risiko, von DCIS oder LCIS fortzuschreiten?
Ihre Lebensstilentscheidungen beeinflussen maßgeblich das Risiko, dass DCIS und LCIS zu invasivem Brustkrebs fortschreiten. Ein gesundes Gewicht zu halten, regelmäßig Sport zu treiben, den Alkoholkonsum zu begrenzen und das Rauchen zu vermeiden, kann Ihr allgemeines Risiko verringern. Außerdem hilft die sorgfältige Verwaltung der Hormontherapie und die Befolgung von Empfehlungen zur Vorsorgeuntersuchung, Veränderungen frühzeitig zu erkennen. Während einige Faktoren außerhalb Ihrer Kontrolle liegen, können Sie durch gesunde Gewohnheiten Ihr Risiko für eine Progression senken und Ihre langfristige Brustgesundheit verbessern.
Gibt es spezielle bildgebende Verfahren, um DCIS von benignen Läsionen zu unterscheiden?
Sie können Mammographie als primäres bildgebendes Verfahren verwenden, um DCIS von benignen Läsionen zu unterscheiden. Es zeigt häufig Mikrokalkablagerungen, die charakteristisch für DCIS sind, insbesondere in frühen Stadien, während benigne Läsionen tendenziell andere Merkmale aufweisen. Zusätzliche Bildgebungsverfahren wie Brust-MRT bieten einen detaillierten Gewebekontrast und können helfen, das Ausmaß von DCIS zu bestimmen, insbesondere in unsicheren Fällen. Ultraschall kann unterstützend sein, ist jedoch weniger spezifisch für die Erkennung von DCIS.
Was sind die neuesten personalisierten Behandlungsoptionen für DCIS und LCIS?
Denken Sie an personalisierte Behandlungsoptionen wie an Ihren maßgeschneiderten Anzug—entwickelt, um perfekt auf Ihre individuellen Bedürfnisse abgestimmt zu sein. Für DCIS könnten Sie von molekularer Profilierung, Genexpressionsanalysen oder genomischer Testverfahren profitieren, um Entscheidungen bezüglich Operation, Strahlentherapie und hormoneller Behandlung zu treffen. Das Management von LCIS legt zunehmend Wert auf Risikoabbau und Überwachung. Neue Technologien, wie Einzelzellanalyse, helfen dabei zu erkennen, welche Läsionen möglicherweise fortschreiten, sodass Sie Überbehandlung vermeiden und sich auf Strategien konzentrieren können, die am besten zu Ihrem individuellen Risiko passen.
Wie beeinflusst rassische Ungleichheit die Ergebnisse und Behandlungsansätze?
Rassistische Ungleichheiten wirken sich erheblich auf die Ergebnisse und Behandlungsmöglichkeiten bei Brustkrebs aus. Sie könnten einem höheren Risiko für ungünstige Ergebnisse ausgesetzt sein, wenn Sie schwarz sind, bedingt durch Faktoren wie verzögerte Diagnosen, eingeschränkten Zugang zu hochwertiger Versorgung und biologische Unterschiede. Diese Ungleichheiten können zu weniger aggressiver Behandlung oder schlechterer Prognose führen. Um diese Lücken zu schließen, sind personalisierte Strategien erforderlich, die Ihre Herkunft berücksichtigen, um einen gleichberechtigten Zugang zu Früherkennung, maßgeschneiderten Therapien und kontinuierlicher Unterstützung zu gewährleisten.
Fazit
Das Verständnis der Nuancen zwischen DCIS und LCIS hilft Ihnen, die frühen Anzeichen von Veränderungen in der Brust zu erkennen. Denken Sie daran, dass diese präkanzerösen Zustände wie leise Flüstertöne sind – manchmal warnend, manchmal harmlos. Indem Sie informiert und wachsam bleiben, haben Sie die Macht, potenzielle Probleme frühzeitig zu erkennen, ähnlich einem Leuchtturm, der Schiffe sicher nach Hause führt. Ihr Bewusstsein wird zum Leuchtfeuer, das Unsicherheit in Handeln verwandelt, und Sie daran erinnert, dass frühe Erkennung Ihr wertvollster Verbündeter im Schutz Ihrer Gesundheit ist.